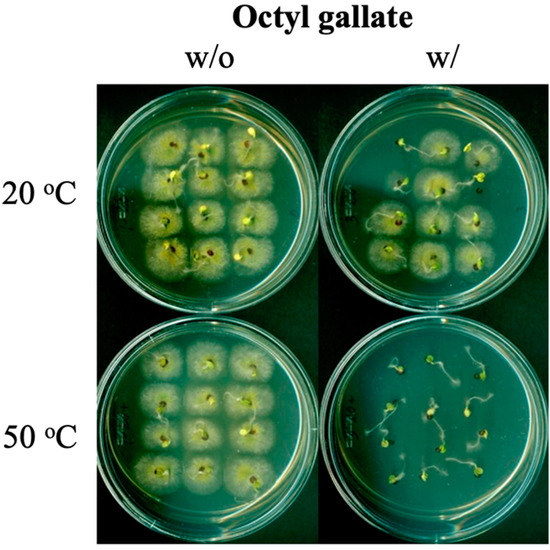

1. Error in Figure
In the original publication [1], there was a mistake in Figures 1 and 2 as published. The benzaldehyde analog “octyl gallate (OG)” was described as benzaldehyde. The corrected Figure 1 and Figure 2 appear below.

Figure 1.
Structure of octyl gallate tested in this study.
Figure 2.
Representative assay showing enhanced seed sanitation via octyl gallate-mediated heat sensitization (hurdle technology). Co-treatment of octyl gallate at 3 mM and mild heat (50 °C) for 20 min completely inhibited the growth of A. flavus on the surface of seeds while the frequency of seed germination was unaffected.
2. Text Correction
There was an error in the original publication. The benzaldehyde analog “octyl gallate (OG)” was mentioned as benzaldehyde.
A correction has been made to Title, Abstract, Keywords, Paragraphs 5, 6, 7 and 8:
Title: Octyl Gallate Use to Protect Seeds from Foodborne Fungal Pathogens
Abstract: There is limited efficacy with conventional seed sanitation methods, directly affecting food safety. Insufficient elimination of mycotoxin-producing fungi contaminating seed surfaces can result in high mycotoxin contamination. In this study, a new seed sanitation formula was investigated by examining molecules repurposed from the United States Food and Drug Administration (FDA)-approved food additives as active ingredients. The selected benzaldehyde analog, octyl gallate (OG; octyl 3,4,5-trihydroxybenzoic acid), previously shown to inhibit mycotoxin production, could function as heat-sensitizing agents when co-applied with mild heat. The co-application substantially enhanced the sanitation efficacy against fungi contaminating crop seeds, whereas the seed germination rate was unaffected. Therefore, OG-based heat sensitization could be a promising tool to achieve safe and cost-effective pathogen control in agriculture/food production.
Keywords: antifungal; benzaldehyde analogs; drug repurposing; food safety; heat sensitization; mycotoxins; octyl gallate (OG); seed sanitation
Paragraph 5: Antimicrobial assay: The heat-sensitizing effect of benzaldehyde analogs, currently used as food additives/derivatives [8], was examined using the mycotoxin-producing fungus Aspergillus flavus. Test samples were treated with mild heat (57.5 °C) or maintained at room temperature (RT; 22.0 °C), then entire samples were cultured for 48 h at 35 °C onto the recovery agar (potato dextrose agar (PDA)) plates. Then, the most effective benzaldehyde analog, octyl gallate (OG; octyl 3,4,5-trihydroxybenzoic acid) (Figure 1, structure), was examined further at 0.1 to 0.3 mM to determine the optimum treatment condition (mild heat (57.5 °C) or RT (22.0 °C)).
Paragraph 6: Antifungal seed disinfection assay: Effects of OG plus mild heat (hurdle technology) on seed sanitation was performed on Brassica rapa (cabbage) seeds. For seed treatments, the co-application of OG (3 mM) and mild heat (50 °C) (20 to 30 min) was investigated on A. flavus-contaminated seeds. The germination of seeds and fungal growth on the surfaces of germinated seeds were monitored for 7 days. Statistical analysis (student’s t-test) was performed according to “Statistics to use” [9], where a p < 0.05 was considered significant.
Paragraph 7: As shown in Figure 2, co-treatment with OG at 3 mM and mild heat (50 °C) for 20 min completely inhibited the growth of A. flavus, while the germination frequency of the crop seeds was not affected when compared to the control. Either 2 mM or 4 mM OG treatments were less effective compared to the 3 mM treatment, namely, fungal contamination was observed at 2 mM or less seed germination at 4 mM of OG, respectively.
Paragraph 8: In summary, the new utility of repurposed OG as a heat-sensitizing agent has been identified; OG exhibited potent heat-sensitizing capability. Thus, results from this study provide means that can enhance the capacity of accepted intervention strategies, such as pasteurization/heat treatment, or alternatives to toxic antifungal agents, such as the seed disinfection agents Thiram, Ferbam, and Ziram; the Pest Management Regulatory Agency (PMRA) of Canada announced the cancellation of the registration of these products in 2018 [10]. It is speculated that the prooxidant activity of OG can disrupt the sensitive structures in microbes, effectively preventing pathogen growth in seeds. Heat sensitization developed in this study will improve the efficacy of antimicrobial practices and achieve safe, rapid, energy-effective, and cost-effective pathogen elimination on seeds or during agriculture or food processing.
The authors state that the scientific conclusions are unaffected. This correction was approved by the Academic Editor. The original publication has also been updated.
Reference
- Kim, J.H.; Chan, K.L. Benzaldehyde Use to Protect Seeds from Foodborne Fungal Pathogens. Biol. Life Sci. Forum 2022, 18, 7. [Google Scholar] [CrossRef]
Disclaimer/Publisher’s Note: The statements, opinions and data contained in all publications are solely those of the individual author(s) and contributor(s) and not of MDPI and/or the editor(s). MDPI and/or the editor(s) disclaim responsibility for any injury to people or property resulting from any ideas, methods, instructions or products referred to in the content. |
© 2023 by the authors. Licensee MDPI, Basel, Switzerland. This article is an open access article distributed under the terms and conditions of the Creative Commons Attribution (CC BY) license (https://creativecommons.org/licenses/by/4.0/).


